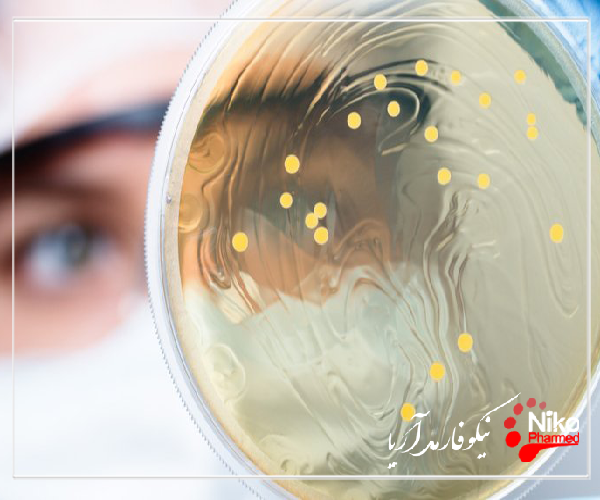
آنتی باکتریال m/آنتی باکتریال

آنتی باکتریال؛محافظت از دستگاه ها با ضد میکروبی های
شرایط اقتصادی کنونی بیمارستان ها را وادار کرده است تا در تلاش برای کاهش هزینه ها و افزایش درآمد، هزینه های خود را به دقت بررسی کنند.
برای کسب اطلاعات بیشتر و دریافت خدمات با ما تماس بگیرید.
در نتیجه، بسیاری از بیمارستان ها هزینه های تامین خود را در زمینه هایی متمرکز می کنند که به آنها در صرفه جویی در هزینه کمک می کند. یکی از حوزههای تمرکز بر پیشگیری از عفونت است.
بیمارستان ها به طور فزاینده ای زمان، تلاش و دلار خود را در راهبردهای جامع کنترل عفونت سرمایه گذاری می کنند تا از بیماران و خطوط نهایی محافظت کنند.
این یک فرصت برای تولیدکنندگان تجهیزات پزشکی است که از رکود اقتصادی نیز رنج می برند. با توجه به اینکه بیمارستانهایی که مایل به سرمایهگذاری در محصولاتی برای مبارزه با عفونتهای اکتسابی بیمارستانی (HAIs) هستند، تولیدکنندگان متوجه میشوند که میتوانند خود را متمایز کنند و نیاز بازار را از طریق دستگاههایی که دارای یک ضد میکروبی هستند برآورده کنند. در نتیجه، بیمارستان ها به دنبال ادغام دستگاه های ضد میکروبی مانند اتصال دهنده های بدون سوزن و کاتترهای مدیریت درد در برنامه های کنترل عفونت خود هستند. این مقاله اطلاعات دقیقی در مورد ضد میکروبی های مبتنی بر نقره و نحوه عملکرد آنها، پیشینه استفاده از ضد میکروبی های مبتنی بر نقره در محصولات پزشکی، و بینش طرفداران کنترل عفونت در مورد استفاده از دستگاه های محافظت شده با نقره مورد تایید FDA برای ترویج تمیزتر و ایمن تر ارائه می دهد. محیط های مراقبت های بهداشتی
مبارزه با HAIs
از بسیاری جهات، بیمارستان ها در حال نبرد سختی با HAI ها هستند که هر ساله حدود 1.7 میلیون عفونت و 99000 مرگ را به خود اختصاص می دهند. محققان تخمین می زنند که هزینه های پزشکی مستقیم HAI ها برای بیمارستان ها از 28.4 میلیارد دلار تا 45 میلیارد دلار در سال است.
عوامل قانونی، بیولوژیکی و اقتصادی فشار زیادی بر بیمارستان ها برای کنترل اپیدمی HAI وارد می کند. و این عفونتها پرهزینه هستند - وزارت بهداشت و خدمات انسانی گزارش داد که هزینه مراقبتهای بهداشتی برای درمان عفونتهای جریان خون استافیلوکوکوس اورئوس برای بیماران مدیکر بیش چندین میلیارد دلار است.
تشدید کننده این مشکل، افزایش ارگانیسم ها یا ابر میکروب های مقاوم به آنتی بیوتیک، از جمله استافیلوکوکوس اورئوس مقاوم به متی سیلین (MRSA) است.
MRSA هر سال چندین هزار نفر را در در کشورهای مختلف می کشد و یک مطالعه اخیر نشان داد که عفونت ها از سال 1999 تا 90 درصد افزایش یافته است.
نقش تجهیزات پزشکی در HAI
چهار دسته از عفونت ها وجود دارد که سه چهارم HAI هایی را تشکیل می دهند که در بیمارستان های مراقبت های حاد رخ می دهد، به شرح زیر:
- عفونت های محل جراحی
- عفونت جریان خون مرتبط و با خط مرکزی.
- پنومونی مرتبط با ونتیلاتور.
- عفونت های دستگاهای ادراری مرتبط با کاتتر.
تحقیقات نشان داده است که وسایل پزشکی مورد استفاده در بدن یا داخل بدن منبع مهمی از HAI هستند. با توجه به اتحاد چند رشته ای علیه عفونت های مرتبط با دستگاه (MADRI)، حداقل نیمی از موارد HAI مربوط به دستگاه های پزشکی است.
این در درجه اول به این دلیل است که دستگاه های پزشکی که روی پوست آسیب دیده قرار می گیرند یا در بدن قرار می گیرند، محیط ایده آلی را برای ارگانیسم های بیماری زا فراهم می کنند.
برخلاف بدن انسان، پلیمرهای دستگاه دارای سیستم ایمنی برای مبارزه با باکتری ها نیستند. در نتیجه، باکتریها سطوح این دستگاهها را مستعمره میکنند، تکثیر میشوند و یک بیوفیلم ایجاد میکنند که یک جامعه سازمانیافته از باکتریها است که توسط یک لایه لجن محافظت میشود.
زمانی که میکروارگانیسمها برای ایجاد یک بیوفیلم روی یک دستگاه پزشکی متحد میشوند، تغییرات سلولی آنها را در برابر درمان آنتیبیوتیکی مقاوم میکند.
نتیبیوتیکها علیه میکروارگانیسمهایی که در فاز رشد پلانکتونیک یا شناور آزاد زندگی میکنند، ساخته و آزمایش میشوند. هنگامی که باکتری ها به سطوح متصل می شوند، شروع به برقراری ارتباط، همکاری و ایجاد یک جامعه ساختاریافته می کنند. آنها ژن ها را تنظیم و کاهش می دهند. آنها عمیقاً تغییر کرده و متفاوت از باکتریهای شناور در آن هستند، بنابراین آنتیبیوتیکهایی که برای کشتن آنها سفارش میدهیم اثر محدودی دارند.
همه دستگاههای پزشکی مستعد تشکیل بیوفیلم هستند، زیرا هر سطحی که روی یا درون بدن قرار میدهیم باعث رشد باکتریها میشود.
این یک مشکل بزرگ برای جامعه مراقبتهای بهداشتی است و ما در رسیدگی به آن ها به خوبی کار انجام نمیدهیم. به HAI ها و منابع این عفونت ها فکر کنید - کاتترهای ادراری، کاتترهای ورید مرکزی، لوله های داخل تراشه همه بیماریهای بیوفیلم تجهیزات پزشکی هستند. و از آنجایی که ما از توانایی درمان موثر این عفونت ها فاصله داریم، پیشگیری کلیدی است.
مقالات بیشتر:
دادن مکانیزم دفاعی به دستگاه ها
برای رفع این کمبود، سازندگان به روش های مختلف از دستگاه ها در برابر میکروب ها محافظت می کنند. یک روش خاص از طریق ضد میکروبی ها است. این به این دلیل است که دستگاه هایی که بیشتر با نرخ بالای عفونت مرتبط هستند مکانیسم های دفاعی خاص خود را دارند و یک سلاح اضافی در زرادخانه خود در برابر HAI ها در اختیار بیمارستان ها قرار می دهند.
دستگاههای ضد میکروبی جایگزین روشهای بهداشتی فعال (مانند شستن دستها و استفاده از ضدعفونیکنندهها) نیستند، بلکه مکمل آنها هستند.
چرا ما در صفر نیستیم؟ نیاز به استراتژیهای گستردهتر کنترل عفونت
چرا صنعت مراقبت های بهداشتی به هیچ وجه به نرخ صفر برای HAI ها نزدیک نیست؟ در حالی که مردم صفحات بی شماری را صرف بحث در مورد این موضوع کرده اند، می توانم آن را در پنج کلمه برای شما شرح دهم: عدم رعایت دستورالعمل های HAI.
کمتر از 40 درصد از بیمارستان های با دستورالعمل های HAI مطابقت کامل دارند. حتی چیزی به سادگی بهداشت دست، فقط 40 درصد از پرسنل مراقبت های بهداشتی به طور منظم دستورالعمل ها را رعایت می کنند - که باعث می شود 60 درصد آنها را رعایت نکنند. البته دستورالعمل های HAI بسیار گسترده تر از شستن دست است. زیرساختهای ناکافی کنترل عفونت در محیطهای مراقبت غیرحاد نیز امکان خطاهای عمده را فراهم کرده است.
امروزه، به منظور کاهش قابل توجه HAI ها و مبارزه با افزایش تهدید باکتری های مقاوم به آنتی بیوتیک، بسیاری از سازمان های مراقبت های بهداشتی استراتژی های کنترل عفونت گسترده تر و هوشیارتری را اتخاذ می کنند که شامل پیروی دقیق تر از دستورالعمل ها، تغییر رفتار کارکنان و اتخاذ درمان با داروهای ضد میکروبی است.
دستگاه های درمان شده با آنتی بیوتیک برای تکمیل برنامه های پیشگیری از عفونت
تعداد فزاینده ای از سازمان های مراقبت های بهداشتی در حال اجرای استراتژی های گسترده ای برای کنترل عفونت هستند که از دستگاه های پزشکی ضد میکروبی استفاده می کنند. و در حالی که دستگاههای ضد میکروبی جایگزین بهترین شیوهها و توصیههای راهنما نمیشوند، میتوانند نقش مهمی در کاهش بیشتر نرخ عفونت داشته باشند.
دستورالعملهای اخیر صنعت به پذیرش دستگاههای محافظت شده ضد میکروبی در میان مراکز بهداشتی کمک کرده است.
با افزایش تقاضا برای دستگاه های پزشکی محافظت شده با ضد میکروبی، تولیدکنندگان در حال بررسی چگونگی توسعه فناوری های جدید برای رفع نیازهای مشتریان خود هستند.
جلوگیری از رشد باکتری یا کشتن باکتری ها پاسخ به این سوال است که طبق تعریف چه چیزی ضد باکتری است. همه باکتری ها مضر نیستند. با این حال، ما نمی خواهیم باکتری های مضر بدن ما یا وسایلی را که اغلب استفاده می کنیم، آلوده کنند.
محصولات بهداشتی مختلفی برای جلوگیری از رشد باکتری های مضر و از بین بردن آنها ساخته شده است. به خصوص در فرآیند کووید-19 که جهان را تحت تأثیر خود قرار داده است، محصولات ضد باکتری به طور مکرر ظاهر می شوند. محصولات بهداشتی ضد باکتری باید متناسب با خطرات محیطی و زمان صرف شده در این محیط ها استفاده شوند. در صورت امکان استفاده از محصولات آنتی باکتریال برای اطمینان از حداکثر بهداشت انتخاب درستی خواهد بود.
مقالات بیشتر:
تست خون سازگاری و هولیز کنندگی
تشخیص اشرشیا کلی در محصولات پزشکی

خاصیت آنتی باکتریال به چه معناست؟
باکتری هایی که از طریق تماس با بدن و اشیاء انسان منتقل می شوند به تولید مثل ادامه می دهند و قوی تر می شوند مگر اینکه اقدامات احتیاطی انجام شود. استفاده از محصولات بهداشتی توسعه یافته برای توقف رشد باکتری ها و کشتن باکتری ها نتایج موثری به همراه دارد. با این حال، هنگام استفاده از این محصولات باید به نکاتی توجه کرد. به این محصولات می توان برخی مرطوب کننده ها را که بر پایه الکل هستند اضافه کرد تا آسیبی به پوست وارد نشود. هدف اصلی آن جلوگیری از تکثیر و مرگ باکتری های مضر بدون نیاز به آب و صابون است. در صورت امکان استفاده از آب و صابون را نباید در استفاده از محصولات بهداشتی ضد باکتری نادیده گرفت.
محصولاتی که در محصولات آنتی باکتریال باعث خشکی پوست می شوند، عموما به عنوان محصولات بی کیفیت و ناسالم شناخته می شوند. برای رفع خشکی پوست می توان از کرم های مرطوب کننده استفاده کرد. درعوض، می توانید با انتخاب صابون های مایع آنتی باکتریال با خاصیت مرطوب کنندگی، هم دست های خود را تمیز کنید و هم رطوبت مورد نیاز دست های خود را تامین کنید.
به ویژه در اپیدمی ویروس کرونا، یکی از اقدامات بهداشتی که ما علاوه بر رعایت فاصله اجتماعی و ماسک انجام می دهیم، محصولات ضد باکتری است. بیایید با توضیح مختصر آنتی باکتریال شروع کنیم. آنتی باکتریال به معنای «جلوگیری از رشد باکتری» است. می دانیم که تماس یکی از راه های انتقال ویروس کرونا است. به گفته برخی کارشناسان، هر چیزی را که لمس می کنیم می تواند میکروب را به سمت ما بیاورد. ویروس کرونا ویروسی است که از بینی، گوش و چشم عبور می کند. اگر به محلی که قبلاً بزاق یا عطسه شخص دیگری آلوده شده است دست بزنیم و سپس دست خود را روی صورت خود بگذاریم، احتمال انتقال ویروس کرونا را بسیار افزایش می دهیم. به خصوص در ویروس کرونا که می دانیم از طریق بزاق و هوا منتقل می شود، باید به بهداشت دست توجه کرد. ماههاست که تلاش میکنیم این همهگیری را ریشه کن کنیم. ما سعی می کنیم با اقداماتی که انجام می دهیم با ماسک زدن، رعایت فاصله اجتماعی، رعایت قانون 14 روزه و علاوه بر آن با در نظر گرفتن و به کارگیری هر آنچه کارشناسان می گویند، به نحوی از خود محافظت کنیم. با همه گیری ویروس کرونا، تقاضا برای ادکلن های 80 درجه و محصولات ضد باکتری و ژل های ضد باکتری به طور قابل توجهی افزایش یافته است. به خصوص ژل های ضد باکتری در کیف ما ضروری شده اند. در حالی که کلمه آنتی باکتریال در زندگی ما بسیار شلوغ است، ما می خواستیم به ناشناخته های این موضوع بپردازیم.
خاصیت آنتی باکتریال چیست؟
کلمه "ضد باکتری" اغلب در زندگی روزمره، در برنامه های تلویزیونی و در مجلات چاپی یا دیجیتال ظاهر می شود. وقتی به معنی TDK آنتی باکتریال نگاه می کنیم، می بینیم که یک کلمه منشاء فرانسوی است. این به معنای "ممانعت از رشد باکتری ها" است. بیایید از طریق چند پرسش و پاسخ در مورد خواص ضد باکتریایی صحبت کنیم.
1- هر چند وقت یکبار باید از محصولات بهداشتی آنتی باکتریال استفاده کرد؟
به گفته کارشناسان، استفاده از محصولات آنتی باکتریال بستگی به محیطی دارد که مصرف کننده در معرض آن قرار می گیرد. محصولات ضد باکتری برای تامین بهداشت دست در محیط هایی که آب و صابون در دسترس نیست استفاده می شود. محصولات ضد باکتری را می توان در محیط هایی که آب و صابون پس از تماس با سطوح در دسترس نیست استفاده کرد.
2- محتویات محصولات آنتی باکتریال چیست؟
محصولات آنتی باکتریال بهداشت دست را بدون نیاز به آب و صابون تامین می کنند. ماده ای که در چنین محصولاتی بهداشت دست را تامین می کند اتیل الکل است. برخی از عوامل مرطوب کننده نیز می توانند برای جلوگیری از آسیب به پوست اضافه شوند. اما اساس آن اتیل الکل است.
3- آیا ژل های آنتی باکتریال سیستم ایمنی را ضعیف می کنند؟
یکی از کنجکاوترین موضوعات در روزهای اخیر تاثیر محصولات آنتی باکتریال بر سیستم ایمنی است. ژل های ضد باکتری به خوبی دست ها را تمیز کرده و از میکروب ها پاک می کنند. با این حال، هر چه بیشتر از آن استفاده شود، باکتری های روی دست ما قوی تر و در برابر این محصول مقاوم می شوند. بنابراین، اثر محصول ممکن است کاهش یابد و بنابراین ممکن است به اندازه اولین باری که آن را استفاده می کنید، موثر نباشد. نباید فراموش کرد که یکی از بهترین روش های نظافت آب و صابون است.
4- آیا محصولات آنتی باکتریال دست را خشک می کنند؟
در طول دوره ویروس کرونا، بسیاری از ما در دستان خود حساسیت داشتیم. بزرگترین بخش این است که ما مرتب از آب و صابون استفاده می کنیم و هر چیزی را که از بازار می آید با آب صابون می شوییم. با این حال، نباید فراموش کرد که ژل های ضد باکتری نیز می توانند دست ها را خشک کنند. الکل موجود در این نوع محصول به اندازه کافی قوی است که دست ها را خشک می کند. با استفاده منظم از کرم دست و مرطوب کننده می توان از اثرات منفی ژل های ضد باکتری جلوگیری کرد.
تقریباً در همه جا می توانیم محصولات ضد باکتریایی پیدا کنیم. به طور اجتناب ناپذیر تقاضای ما برای محصولات آنتی باکتریال در حال افزایش است، به ویژه با توجه به هشدارهای کارشناسان در مورد بهداشت دست ها به دلیل همه گیری ویروس کرونا. با این حال، اگرچه مفید است، استفاده بیش از حد از همه چیز مضر است. به عنوان مثال، افراد مبتلا به اگزما، زخم دست یا پسوریازیس باید با پزشک مشورت کنند و از چنین محصولاتی استفاده کنند. بهداشت مهم است و از بیماری ها محافظت می کند، اما این روزها که سردرگمی های زیادی وجود دارد، استفاده از این محصولات با تایید پزشک بسیار سالم تر خواهد بود، نه با اطلاعات شنیداری.
داروهای ضد باکتری از باکتری ها یا قارچ ها مشتق می شوند یا ممکن است کاملاً مصنوعی باشند. از نظر فنی، "آنتی بیوتیک" که اغلب مترادف با "داروی ضد باکتری" (از جمله در این راهنما) استفاده می شود، فقط به ضد میکروبی های مشتق شده از باکتری ها یا قارچ ها اشاره دارد.
آنتی بیوتیک ها مکانیسم های عمل مختلفی دارند، مانند:
مهار سنتز دیواره سلولی
افزایش نفوذپذیری دیواره سلولی
تداخل با سنتز پروتئین و متابولیسم اسید نوکلئیک و سایر فرآیندهای متابولیک (به عنوان مثال، سنتز اسید فولیک)
گاهی اوقات، آنتیبیوتیکها با سایر داروها تداخل دارند و با افزایش یا کاهش متابولیسم یا مکانیسمهای دیگر، سطح سرمی آنها را افزایش یا کاهش میدهند. مهمترین تداخلات از نظر بالینی شامل داروهایی با شاخص درمانی پایین است (یعنی سطوح سمی نزدیک به دو سطح درمانی است). همچنین، مواد دیگر می توانند سطح دو آنتی بیوتیک را افزایش یا کاهش دهند.
بسیاری از آنتیبیوتیکها از نظر شیمیایی مرتبط هستند و به کلاسهایی دستهبندی میشوند. اگرچه داروهای هر کلاس شباهتهای ساختاری و عملکردی دارند، اما فرکانسها، فارماکولوژی و طیف فعالیتهای متفاوتی دارند.
انتخاب و استفاده از آنتی بیوتیک ها
آنتی بیوتیک ها باید فقط در صورت وجود شواهد بالینی یا آزمایشگاهی از عفونت باکتریایی استفاده شوند. استفاده برای doenças virais یا تب های غیر اختصاصی در بیشتر دو مورد نامناسب است. بیمار را بدون هیچ سودی در معرض عوارض جانبی قرار می دهد و به مقاومت باکتریایی کمک می کند.
بعضی از عفونت های باکتریایی (همچون آبسه ها، عفونت های جسم خارجی) نیازمند به مداخله جراحی هستند، چون به آنتی بیوتیک های جدا شونده پاسخی نمی دهند.
به طور کلی، پزشکان باید سعی کنند از آنتی بیوتیک ها با محدودترین طیف ممکن و در کوتاه ترین مدت استفاده کنند.
طیف فعالیت
کشت و تست های حساسیت آنتی بیوتیکی برای انتخاب دارو در عفونت های شدید ضروری است. Contudo یا درمان در اکثر مواقع باید قبل از نتیجه کشت شروع شود. انتخاب آنتی بیوتیک باید با در نظر گرفتن قابل اثبات ترین میکروارگانیسم های آلوده کننده (انتخاب تجربی دو آنتی بیوتیک) انجام شود.
داروهای انتخاب شده، چه نتایج کشت در نظر گرفته شود یا نه، باید طیفی از فعالیت یا بیشترین محدودیت ممکن را برای کنترل عفونت داشته باشند. برای درمان تجربی عفونتهای شدید که ممکن است هر عامل بیماریزایی (مثلاً تب در یک بیمار نوتروپنیک) یا عوامل بیماریزای متعدد (مثلاً عفونت بیهوازی مختلط) را درگیر کند، آنتیبیوتیک طولانیطیف توصیه میشود. مستعدترین میکروارگانیسم ها و حساسیت به آنتی بیوتیک ها بسته به محل (در همان شهر یا همان بیمارستان) متفاوت است و می تواند از یک ماه به ماه دیگر تغییر کند. داده ها باید در مورد حساسیت آنتی بیوگرام ها به دست آید و در صورت امکان از آنها برای هدایت درمان تجربی استفاده شود. آنتی بیوگرام ها الگوهای حساسیت به آنتی بیوتیک های خاص منطقه ای دو پاتوژن رایج و آنتی بیوتیک های رایج را خلاصه می کنند.
ترکیب آنتیبیوتیکها اغلب در عفونتهای شدید ضروری است، هم به این دلیل که درمان گونههای متعددی از باکتریهای عفونی را ارائه میکنند و هم به این دلیل که به طور هم افزایی علیه یک گونه از باکتریها عمل میکنند. سینرژیسم معمولاً به عنوان یک اثر ضد باکتریایی سریعتر و کاملتر از ترکیبی از آنتی بیوتیکها نسبت به هر دو آنتی بیوتیک تعریف می شود. یک مثال رایج یک آنتی بیوتیک فعال است که دیواره سلولی را پیر می کند (به عنوان مثال، بتالاکتام یا وانکومایسین) همراه با یک آمینوگلیکوزید.
مقالات بیشتر:
تشخیص اشرشیا کلی در محصولات پزشکی
تشخیص سودوموناس در محصولات پزشکی
تشخیص سالمونلا در محصولات پزشکی
اثربخشی
اثر ضد باکتریایی در داخل بدن توسط عوامل زیادی تعیین می شود، مانند
فارماکوکینتیک: طول مدت دو سطح آنتی بیوتیک که توسط عواملی مانند جذب، توزیع (غلظت در مایعات و بافت ها و اتصال به پروتئین) و سرعت متابولیسم و دفع اصلاح می شود.
فارماکودینامیک: فعالیت ضد میکروبی غلظت های موضعی آنتی بیوتیک های غیر بیماری زا و پاسخ پاتوژن، از جمله مقاومت
وجود اجسام خارجی
منبع عفونی را کنترل کنید
تداخل دارویی یا مواد بازدارنده
مکانیسم های دفاعی میزبان
داروهای ضد باکتری باکتری ها را از بین می برند. داروهای باکتریواستاتیک رشد باکتری را در شرایط آزمایشگاهی مهار یا قطع می کنند. این تعاریف مطلق نیستند; باکتریوستاتیک ها ممکن است برخی از گونه های باکتریایی را از بین ببرند و باکتری کش ها ممکن است فقط رشد برخی از گونه های باکتریایی حساس را مهار کنند. روشهای کمی دقیقتر، حداقل غلظت آنتیبیوتیک آزمایشگاهی را شناسایی میکنند که قادر به مهار رشد باکتری (حداقل غلظت مهارکننده، [MIC]) یا از بین بردن آن (حداقل غلظت باکتریکشی، [MCB]) است. یک آنتی بیوتیک با فعالیت باکتری کش می تواند حذف باکتری را بهبود بخشد زمانی که دفاع میزبان به صورت موضعی به دلیل عفونت (مثلاً در مننژیت یا اندوکاردیت) یا سیستمیک (مثلاً در اشکال سیستم ایمنی، نوتروپنیک یا سایر بیماران) مختل می شود. در همین حال، داده های بالینی محدودی وجود دارد که نشان می دهد یک داروی ضد باکتری باید بر یک داروی باکتریواستاتیک ترجیح داده شود، صرفاً بر اساس طبقه بندی. انتخاب دو دارو برای به دست آوردن اثربخشی ایدهآل باید بر اساس نحوه تغییر غلظت دارو در طول زمان در رابطه با MIC باشد، نه اینکه بر اساس نوع فعالیت آنتیبیوتیک، باکتریکشی یا باکتریوستاتیک باشد.
آنتی بیوتیک ها را می توان به 3 دسته کلی (1) با توجه به فارماکوکینتیک که فعالیت ضد میکروبی را بهینه می کند (فارماکودینامیک) گروه بندی کرد:
وابسته به غلظت: مقداری که حداکثر غلظت از MIC بیشتر می شود (معمولاً به صورت نسبت حداکثر غلظت به MIC بیان می شود) با فعالیت ضد میکروبی ارتباط بهتری دارد.
وابسته به زمان: مدت زمان مصرف، نه غلظت آنتی بیوتیک بیش از MIC (به طور کلی، به عنوان درصد زمان بالاتر از MIC بیان می شود) با فعالیت ضد میکروبی ارتباط بهتری دارد.
وابسته به قرار گرفتن در معرض: مقدار داروی داده شده در رابطه با MIC (مقدار دارو منطقه 24 ساعته در منحنی غلظت-زمان (AUC24) است؛ نسبت بین AUC24 و MIC بهترین ارتباط را با فعالیت ضد میکروبی دارد.
آمینوگلیکوزیدها، فلوروکینولون ها و داپتومایسین فعالیت باکتری کشی وابسته به غلظت را نشان می دهند. افزایش غلظت آنها از سطوح کمی بالاتر از MIC به سطوح بسیار بالاتر از MIC، سرعت و میزان فعالیت باکتری کشی آنها را افزایش می دهد. همچنین، اگر غلظت ها حتی برای مدت کوتاهی از MIC فراتر رود، آمینوگلیکوزیدها و فلوروکینولون ها اثر پس از آنتی بیوتیک (EPA) بر روی باکتری های باقی مانده دارند. مدت زمان EPA نیز به غلظت بستگی دارد. اگر EPA طولانی باشد، ممکن است سطوح دارو برای دورههای طولانیتر بدون از دست دادن اثربخشی کمتر از MIC باشد، که امکان دوز کمتری را فراهم میکند. در نتیجه، آمینوگلیکوزیدها و فلوروکینولونها معمولاً بهعنوان یک بولوس متناوب مؤثرتر هستند که به حداکثر سطح سرمی آزاد (یعنی بخشی از آنتیبیوتیک متصل به پروتئین سرم) ≥ 10 برابر MIC باکتریها میرسند. به طور کلی حداقل سطوح مهم نیستند.
بتالاکتام ها، کلاریترومایسین و اریترومایسین فعالیت باکتری کشی وابسته به زمان از خود نشان می دهند. افزایش غلظت آنها در بالای MIC، فعالیت باکتری کشی را افزایش نمی دهد، و ریشه کن کردن in vivo تمایل به پایین دارد. همچنین، از آنجایی که پس از باقی ماندن غلظتها در زیر MIC (این حداقل اثر پس از آنتیبیوتیک است)، هیچ یا بسیار کوتاهی از رشد باکتریها مهار نمیشود، بتالاکتامها زمانی مؤثرتر هستند که سطح سرمی داروی آزاد (دارو بدون اتصال به پروتئین های سرم) بیش از 50٪ از MIC دو برابر بیشتر است. از آنجایی که سفتریاکسون نیمه عمر طولانی دارد (حدود 8 ساعت)، سطح سرمی آزاد از MIC پاتوژن های حساس به موتوژن در کل فاصله دوز 24 ساعته فراتر می رود. با این حال، برای بتالاکتام هایی که نیمه عمر آنها ≤ 2 ساعت است، تجویز مکرر یا انفوزیون مداوم به منظور بهینه سازی زمان بالای MIC ضروری است.
بیشتر ضد میکروبی ها دارای فعالیت ضد باکتریایی وابسته به قرار گرفتن در معرض هستند که بهترین مشخصه آن با نسبت AUC به MIC است. ونکومایسین، تتراسایکلین ها و کلیندامایسین نمونه های خوبی هستند.

مرجع اثربخشی
- رویکرد PK/PD به درمان آنتی بیوتیکی
تجویز خوراکی سطوح سرمی عالی بسیاری از آنتی بیوتیک ها را فراهم می کند و تقریباً به همان سرعت تزریق داخل وریدی (IV) است. با این حال، تجویز داخل وریدی داروها با تظاهرات خوراکی در دسترس در شرایط زیر ارجحیت دارد:
آنتی بیوتیک های خوراکی قابل تحمل نیستند (مثلاً هنگام استفراغ)
جذب خوراکی دو آنتی بیوتیک ضعیف است (مثلاً به دلیل افزایش جذب پس از جراحی روده، اختلال در حرکت روده به دلیل استفاده از مواد افیونی و غیره).
بیمار بسیار جدی که پرفیوژن درمان گوارشی او ممکن است مختل شود، یا حتی زمانی که تاخیر کوتاه در مصرف خوراکی ممکن است مضر باشد.
جمعیت های خاص
دوزها و طرح های آنتی بیوتیک ها ممکن است در موارد زیر نیاز به اصلاح داشته باشند:
شیردهی
افراد احمق
بیماران مبتلا به نارسایی کلیوی (جدول دوز عادت دو آنتی بیوتیک معمول تجویز شده را ببینید)
بیماران مبتلا به نارسایی کبد (معمولاً برای سفوپرازون، کلرامفنیکل، مترونیدازول، ریفابوتین و ریفامپیسین)
بیماران چاق
بیماران مبتلا به فیبروز کیستیک
بارداری و تغذیه بر انتخاب آنتی بیوتیک تأثیر می گذارد. پنی سیلین ها، سفالوسپورین ها و اریترومایسین از بی خطرترین آنتی باکتریال ها در بارداری هستند. تتراسایکلین ها منع مصرف دارند. اکثر دو آنتی بیوتیک به غلظت هایی می رسند که برای تأثیر یا تغذیه شیر مادر کافی نیست، که گاهی اوقات استفاده از آنها را منع می کند.
مدت زمان
آنتی بیوتیک ها باید تا زمانی که شواهد عینی عفونت سیستمیک (مانند تب، علائم و یافته های غیرطبیعی آزمایشگاهی) برای چند روز وجود نداشته باشد استفاده شود. طرحهای درمانی برای برخی عفونتها (به عنوان مثال، اندوکاردیت، سل، استئومیلیت یا جذام) برای جلوگیری از عود، هفتهها تا ماهها ادامه مییابد.
مقالات بیشتر:
تشخیص کاندیدا در محصولات پزشکی
عوارض
عوارض درمان با آنتی بیوتیک عفونت ثانویه توسط باکتری های غیر حساس یا قارچ ها و اثرات نامطلوب پوستی، کلیوی، خونی، عصبی و گوارشی است.
عوارض جانبی مستلزم قطع مکرر دارو و جایگزینی آن با آنتی بیوتیک دیگری است که پاتوژن به آن حساس است. در برخی موارد، این جایگزین وجود ندارد.
مقاومت آنتی بیوتیکی
مقاومت در برابر یک آنتی بیوتیک ممکن است ذاتی یک گونه باکتری خاص باشد یا ممکن است در نتیجه جهش یا بدست آوردن ژن هایی از میکروارگانیسم دیگری که مقاومت باکتریایی را کد می کند، به دست آید. مکانیسمهای مقاومت متفاوتی توسط این ژنها کدگذاری میشوند (جدول مکانیسمهای رایج مقاومت آنتیبیوتیکی را ببینید). ژن های مقاومت را می توان با مکانیسم های زیر بین 2 سلول باکتری منتقل کرد:
تبدیل (انتقال یک قطعه DNA از میکروارگانیسم دیگر)
انتقال (عفونت توسط باکتریوفاژ)
کونژوگاسیون (تغییر ماده ژنتیکی به شکل هر دو پلاسمید که تکثیر شده مستقل DNA خارج کروموزومی هستند و ترانسپوزون ها که قطعات متحرک DNA کروموزومی هستند)
پلاسمیدها و ترانسپوزون ها می توانند به سرعت ژن های مقاومت را گسترش دهند.
استفاده از آنتی بیوتیک ها ترجیحاً باکتری های غیر مقاوم را از بین می برد و نسبت باکتری های مقاوم باقی مانده را افزایش می دهد. این واقعیتی است که نه تنها در مورد باکتری های بیماری زا، بلکه در مورد میکروبیوتای طبیعی نیز رخ می دهد. میکروبیوتای مقاوم معمولی به عنوان مخزنی برای ژن های مقاوم عمل می کند که می توانند به پاتوژن های آینده گسترش یابند.





